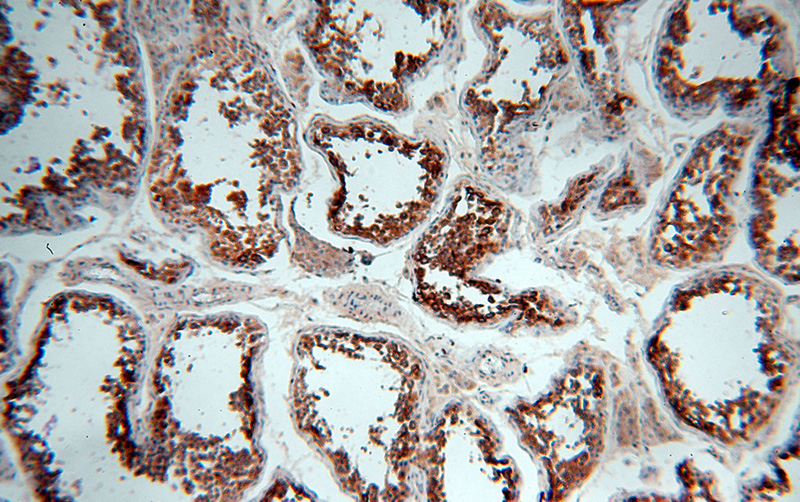
Immunohistochemical of paraffin-embedded human testis using Catalog No:111380(HDAC6 antibody) at dilution of 1:50 (under 10x lens)

-
Product Name
HDAC6 antibody
- Documents
-
Description
HDAC6 Rabbit Polyclonal antibody. Positive IP detected in K-562 cells. Positive WB detected in K-562 cells, HeLa cells, HepG2 cells, HT-1080 cells, human liver tissue, MCF7 cells. Positive IHC detected in human testis tissue. Observed molecular weight by Western-blot: 160kd
-
Tested applications
ELISA, WB, IHC, IP
-
Species reactivity
Human, Mouse, Rat; other species not tested.
-
Alternative names
FLJ16239 antibody; HD6 antibody; HDAC6 antibody; histone deacetylase 6 antibody; JM21 antibody; KIAA0901 antibody
-
Isotype
Rabbit IgG
-
Preparation
This antibody was obtained by immunization of HDAC6 recombinant protein (Accession Number: BC013737). Purification method: Antigen affinity purified.
-
Clonality
Polyclonal
-
Formulation
PBS with 0.02% sodium azide and 50% glycerol pH 7.3.
-
Storage instructions
Store at -20℃. DO NOT ALIQUOT
-
Applications
Recommended Dilution:
WB: 1:500-1:5000
IP: 1:500-1:5000
IHC: 1:20-1:200
-
Validations

K-562 cells were subjected to SDS PAGE followed by western blot with Catalog No:111380(HDAC6 antibody) at dilution of 1:1000

IP Result of anti-HDAC6 (IP:Catalog No:111380, 5ug; Detection:Catalog No:111380 1:1000) with K-562 cells lysate 11000ug.
Immunohistochemical of paraffin-embedded human testis using Catalog No:111380(HDAC6 antibody) at dilution of 1:50 (under 10x lens)

Immunohistochemical of paraffin-embedded human testis using Catalog No:111380(HDAC6 antibody) at dilution of 1:50 (under 40x lens)
-
Background
Histone deacetylases(HDAC) are a class of enzymes that remove the acetyl groups from the lysine residues leading to the formation of a condensed and transcriptionally silenced chromatin. At least 4 classes of HDAC were identified. HDAC6 is a member of the class II mammalian histone deacetylases. It possesses two separate putative catalytic domains. Both catalytic domains are fully functional HDACs and contribute independently to the overall activity of HDAC6 protein. A very potent NES is present at the amino-terminus of HDAC6, which was found to play an important role in regulating the shuttling of HDAC6 protein between cytoplasm and nucleus. The shuttling process may be a critical regulatory mechanism of HDAC6 function. The expression of HDAC6 is tightly linked to the state of cell differentiation. HDAC6 may participate in coordinating expression of a group of genes involved in the remodelling of chromatin during cell differentiation. HDAC6 has some splicing variants such as P114(~130kd), P131(~160kd).This antibody is a rabbit polyclonal antibody raised against residues near the C terminal of human HDAC6.
-
References
- Wang X, Liu J, Zhen J. Histone deacetylase 4 selectively contributes to podocyte injury in diabetic nephropathy. Kidney international. 86(4):712-25. 2014.
- Cai M, Hu Z, Liu J. Expression of hMOF in different ovarian tissues and its effects on ovarian cancer prognosis. Oncology reports. 33(2):685-92. 2015.
Related Products / Services
Please note: All products are "FOR RESEARCH USE ONLY AND ARE NOT INTENDED FOR DIAGNOSTIC OR THERAPEUTIC USE"
